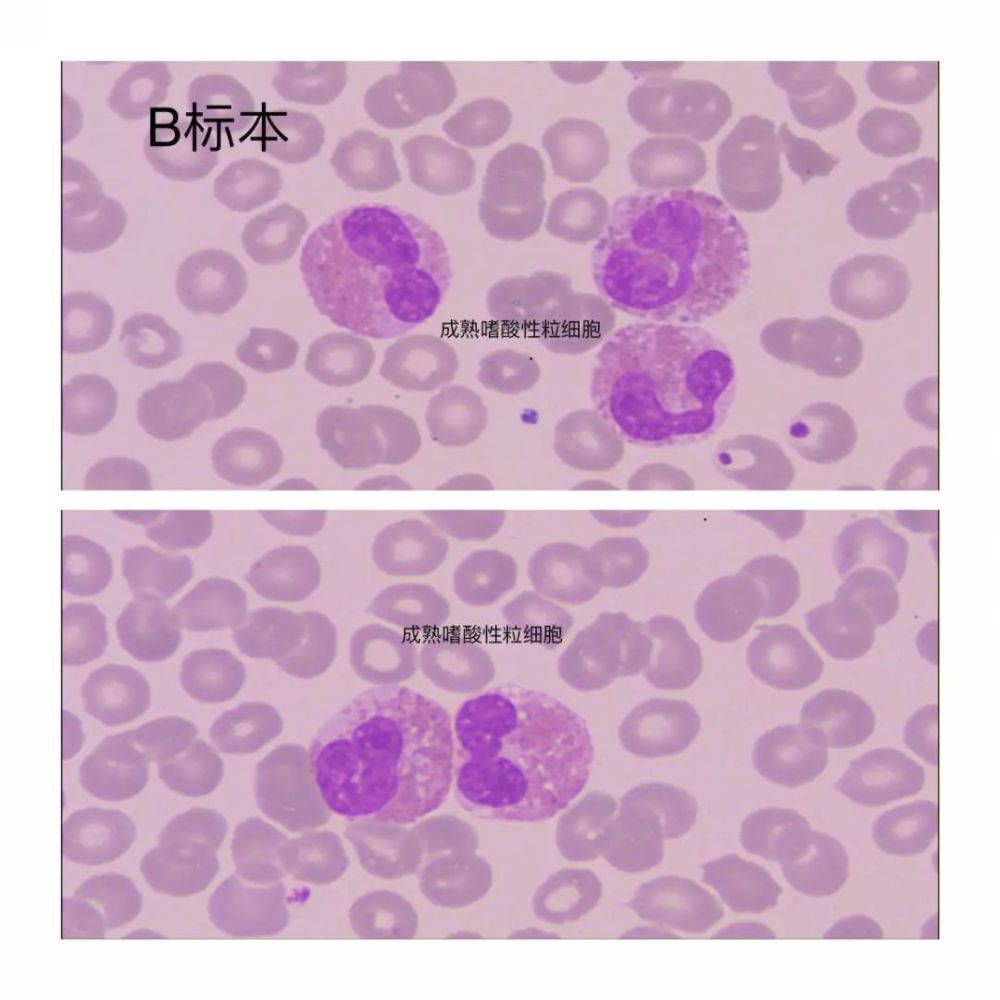
c标本中有少量幼稚嗜酸性粒细胞,镜检结果如下

嗜酸性粒细胞镜下图片

由于嗜酸性粒细胞比例异常增高,推片镜检如图2,3,嗜酸性粒细胞多见
图片尺寸1000x1333
嗜酸性粒细胞,嗜碱性粒细胞的生理功能是什么,求详细答案
图片尺寸700x504
图2由于嗜酸性粒细胞比例异常增高,推片镜检如图2,3,嗜酸性粒细胞多见
图片尺寸1000x1333
图1血涂片瑞姬染色镜下可见许多典型的嗜酸性粒细胞,手工计数比例和
图片尺寸1000x868
嗜酸性粒细胞.jfif
图片尺寸533x400
第二天一早笔者就到临床给患者采末梢血涂片,镜下可见嗜酸性粒细胞
图片尺寸700x620
嗜酸性中幼粒细胞 08
图片尺寸650x484
涂片显示嗜酸性粒细胞
图片尺寸1200x800
嗜酸粒细胞图册_百度百科
图片尺寸290x202
图1血涂片瑞姬染色镜下可见许多典型的嗜酸性粒细胞,手工计数比例和
图片尺寸1080x915
c标本中有少量幼稚嗜酸性粒细胞,镜检结果如下
图片尺寸1000x1000
嗜酸性粒细胞增多症
图片尺寸500x444
已知促嗜酸性粒细胞增多的细胞因子有白细胞介素-3(il-3),il-5和粒-巨
图片尺寸220x217
嗜酸性粒细胞粒细胞
图片尺寸1200x960
结果也是同阅片机的结果一样,镜下均为中性粒细胞,嗜酸性粒细胞在正常
图片尺寸865x577
请大家帮我看一下这个he切片有没有嗜酸性粒细胞
图片尺寸450x509
hes,嗜酸性粒细胞增多综合征,通常会出现在多种恶性肿瘤患者中
图片尺寸640x426
嗜酸性粒细胞增多症外周血涂片
图片尺寸704x527
求助血细胞(中性粒~嗜酸性粒~淋巴)区别及图片
图片尺寸800x534
什么是嗜酸性粒细胞?偏高有什么危害性?
图片尺寸605x407